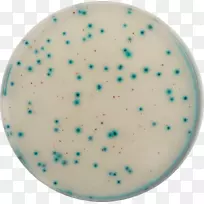
e。大肠杆菌生长培养基-空若网 e。大肠杆菌生长培养基-空若网

欢迎您 本站地址:
首页
图片素材
塑料矩形设计-图片素材分享-空若网
图片素材推荐-空若网
e。大肠杆菌生长培养基

电脑图标下载剪辑艺术反馈按钮

产品设计绿松石角蒸汽熨斗

气球 水彩 油漆

放大镜 蓝色 浅绿色

冰淇淋 系列 纸张

幼儿剪贴画-小象

护目镜太阳镜塑料制品-斯科特护目镜

蓝色 水 米

产品设计图形字体背景

拱形丝带 浅绿色 绿松石色

绿松石有机体-紫色气泡

线线

鱼 卡通 尾巴

商标字体设计

商标桌面壁纸.设计

LOGO品牌为我租用Pty有限公司字体线

水彩画 油漆 湿墨水

衬衫连衣裙绿松石长背心针织

车-车

绿松石品牌字型

产品设计碗m塑料

商标桌面壁纸.设计

提尔绿松石圆圈-注册按钮

网页开发图标 编码图标 用户界面图标

绿松石设计

水彩画 油漆 湿墨水

卡通 气球 绿松石
温馨提示 扫描下方二维码,访问手机版。